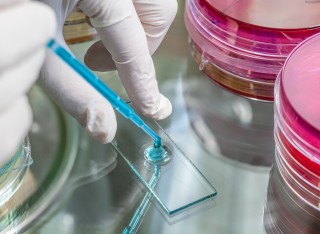

Professor Graham Stewart
About
University roles and responsibilities
- Bacteriology Section Leader
- Chair Board of Examinations
- Professor of Molecular Bacteriology
News
In the media
ResearchResearch interests
Mycobacterium tuberculosis
Tuberculosis (TB) is one of the most important infectious diseases of mankind, claiming 30,000 lives every week. One third of the world's population carry an asymptomatic persistent infection with a 10% risk of progression to active disease. Of the 10 million new cases of tuberculosis every year, more than half a million are caused by strains of Mycobacterium tuberculosis that have acquired multidrug-resistance. BCG is currently the only vaccine used against TB and while it is successful in protecting against disease in children, it is ineffective against adult pulmonary TB. Improvement in diagnosis, drugs and vaccines for tuberculosis will be needed to control this epidemic.
Mycobacterium bovis
Bovine tuberculosis is the most important veterinary health problem in the UK. The projected economic burden to the UK over the next decade is predicted to be £1 billion. Control is likely to require an integrated approach with vaccination of cattle representing a key component. Presently, the M.bovis BCG vaccine represents the most encouraging vaccination option, but it compromises the diagnostic skin test and has a protective efficacy of only ~50-70%.
Research projects
To form a rational platform upon which to develop novel drugs, vaccines and diagnostic agents we are working to understand the molecular basis of how M. tuberculosis and M.bovis are able to establish infection and generate diseaseResearch approach
High-throughput functional genomic studies of M.tuberculosis complex bacteria and their host cells by our lab and others have revealed that virulence is controlled by complex multifactorial interactions between thousands of bacterial and host components. From these interaction networks emerge the properties that characterise the pathogenesis of TB. To understand these networks, our lab makes detailed investigations of molecular interactions in the context of infection systems including human cells and the free living amoeba Dictyostelium discoideum. Our strategy is that more effective drug and vaccine development strategies are based on a higher level of biological understanding.
We are identifying and studying molecular interaction networks associated with the pathogenesis features below:
Mycobacterial modulation of phagosome biology
The success of M.tuberculosis/M.bovis as pathogens relies on an ability to grow inside host macrophages (and other cells) and then to fashion an escape route that modulates inflammation to its benefit. Multiple factors are involved in intracellular survival but key features are the ability of M. tuberculosis to arrest phagosome maturation, transit from the phagosome to the cytoplasm and escape from the host cell.
Mycobacterial control of host cell death
Evidence suggests that M.tuberculosis is able to control the fate of host cells such as macrophages, neutrophils and dendritic cells. Early in infection it is able to inhibit apoptosis to preserve its replicative niche but later it has the capacity to induce an inflammatory form of cell death.
Mycobacterial growth control
A prominent characteristic of M.tuberculosis complex organisms is slow growth. Control of growth is inextricably linked to persistent infection and phenotypic drug resistance. Understanding the mechanisms bacterial replication and growth control will be important to novel drug discovery.
The mycobacterial stress response
Pathogenic mycobacteria must endure a variety of other hostile environments during infection. The bacteria counter these harsh conditions with specific and general stress responses that remodel the physiology, biochemistry and structure of the cell. These mechanisms are an essential component of pathogenicity.
Bioarchaeology
In collaboration with Professor Mike Taylor we aim to understand the evolution and macroecology of leprosy and tuberculosis by studying ancient pathogen DNA in archaeological specimens. Characterisation of individual polymorphisms or even reconstruction of whole genome sequences is possible for mycobacterial infections from over 1000 years ago, allowing accurate phylogenetic and evolutionary models to be developed.
Funding
Financial support for our research is provided by the BBSRC, NC3Rs, European Commission and Commonwealth Scholarship Commission.
Research collaborations
- Johnjoe McFadden
- Andrzej Kierzek
- Mike Taylor
- Suzie Hingley-Wilson
Research interests
Mycobacterium tuberculosis
Tuberculosis (TB) is one of the most important infectious diseases of mankind, claiming 30,000 lives every week. One third of the world's population carry an asymptomatic persistent infection with a 10% risk of progression to active disease. Of the 10 million new cases of tuberculosis every year, more than half a million are caused by strains of Mycobacterium tuberculosis that have acquired multidrug-resistance. BCG is currently the only vaccine used against TB and while it is successful in protecting against disease in children, it is ineffective against adult pulmonary TB. Improvement in diagnosis, drugs and vaccines for tuberculosis will be needed to control this epidemic.
Mycobacterium bovis
Bovine tuberculosis is the most important veterinary health problem in the UK. The projected economic burden to the UK over the next decade is predicted to be £1 billion. Control is likely to require an integrated approach with vaccination of cattle representing a key component. Presently, the M.bovis BCG vaccine represents the most encouraging vaccination option, but it compromises the diagnostic skin test and has a protective efficacy of only ~50-70%.
Research projects
Research approach
High-throughput functional genomic studies of M.tuberculosis complex bacteria and their host cells by our lab and others have revealed that virulence is controlled by complex multifactorial interactions between thousands of bacterial and host components. From these interaction networks emerge the properties that characterise the pathogenesis of TB. To understand these networks, our lab makes detailed investigations of molecular interactions in the context of infection systems including human cells and the free living amoeba Dictyostelium discoideum. Our strategy is that more effective drug and vaccine development strategies are based on a higher level of biological understanding.
We are identifying and studying molecular interaction networks associated with the pathogenesis features below:
Mycobacterial modulation of phagosome biology
The success of M.tuberculosis/M.bovis as pathogens relies on an ability to grow inside host macrophages (and other cells) and then to fashion an escape route that modulates inflammation to its benefit. Multiple factors are involved in intracellular survival but key features are the ability of M. tuberculosis to arrest phagosome maturation, transit from the phagosome to the cytoplasm and escape from the host cell.
Mycobacterial control of host cell death
Evidence suggests that M.tuberculosis is able to control the fate of host cells such as macrophages, neutrophils and dendritic cells. Early in infection it is able to inhibit apoptosis to preserve its replicative niche but later it has the capacity to induce an inflammatory form of cell death.
Mycobacterial growth control
A prominent characteristic of M.tuberculosis complex organisms is slow growth. Control of growth is inextricably linked to persistent infection and phenotypic drug resistance. Understanding the mechanisms bacterial replication and growth control will be important to novel drug discovery.
The mycobacterial stress response
Pathogenic mycobacteria must endure a variety of other hostile environments during infection. The bacteria counter these harsh conditions with specific and general stress responses that remodel the physiology, biochemistry and structure of the cell. These mechanisms are an essential component of pathogenicity.
Bioarchaeology
In collaboration with Professor Mike Taylor we aim to understand the evolution and macroecology of leprosy and tuberculosis by studying ancient pathogen DNA in archaeological specimens. Characterisation of individual polymorphisms or even reconstruction of whole genome sequences is possible for mycobacterial infections from over 1000 years ago, allowing accurate phylogenetic and evolutionary models to be developed.
Funding
Financial support for our research is provided by the BBSRC, NC3Rs, European Commission and Commonwealth Scholarship Commission.
Research collaborations
- Johnjoe McFadden
- Andrzej Kierzek
- Mike Taylor
- Suzie Hingley-Wilson
Teaching
Undergraduate
I teach on the following courses:
- Biochemistry BSc (Hons)
- Biological Sciences BSc (Hons)
- Biomedical Science BSc (Hons) / MSci (Hons)
- Food Science and Nutrition BSc (Hons)
- Microbiology BSc (Hons)
- Nutrition BSc (Hons)
- Nutrition and Dietetics BSc (Hons)
- Veterinary Biosciences BSc (Hons)
I teach on the following modules:
- BMS1026: Microbiology: An Introduction to the Microbial World
- BMS1047: Introduction to Molecular Biology and Genetics
- BMS2037: Cellular Microbiology and Virology
- BMS3079: Human Microbial Diseases
Postgraduate
I teach on the MSc Medical Microbiology course.
I teach on the following modules:
- MMIM018: Microbial Genetics and Molecular Biology
- MMIM026: Research Methods 1
- MMIM024: Pathogenesis of Infectious Disease
Publications
Eight burials from the multi-period rural settlement site of Ranelagh near Roscommon town, Ireland, with palaeopathological lesions suggestive of skeletal tuberculosis or brucellosis were examined by ancient DNA (aDNA) testing. Tuberculosis infection (MTB complex DNA) was confirmed in five individuals –an 11th-13th CE adolescent female (14.5-17.5 years), two young adults females (18-35 years, 7th-10th CE), one adolescent of unknown sex and one middle-aged adult (35-50 years, medieval in date). In the latter case, the differential diagnosis included brucellosis due to the presence of small multifocal lytic lesions in the lower spinal vertebrae. However, this individual and all cases tested negative for Brucella species DNA. In two positive cases, lineage 4 (Euro-American) Mycobacterium tuberculosis DNA was identified in extracts obtained from tooth pulp cavities. These are the first archaeological individuals from Ireland to have had tuberculosis infection confirmed through aDNA analysis.
Mycobacterium tuberculosis maintains long-term infections characterised by the need to regulate growth and adapt to contrasting in vivo environments. Here we show that M. tuberculosis complex bacteria utilise reversible ADP-ribosylation of single-stranded DNA as a mechanism to coordinate stationary phase growth with transcriptional adaptation. The DNA modification is controlled by DarT, an ADP-ribosyltransferase, which adds ADP-ribose to thymidine, and DarG, which enzymatically removes this base modification. Using darG-knockdown M. bovis BCG, we map the first DNA ADP-ribosylome from any organism. We show that inhibition of replication by DarT is reversible and accompanied by extensive ADP-ribosylation at the origin of replication (OriC). In addition, we observe ADP-ribosylation across the genome and demonstrate that ADP-ribose-thymidine alters the transcriptional activity of M. tuberculosis RNA polymerase. Furthermore, we demonstrate that during stationary phase, DarT-dependent ADP-ribosylation of M. tuberculosis DNA is required to optimally induce expression of the Zur regulon, including the ESX-3 secretion system and multiple alternative ribosome proteins. Thus, ADP-ribosylation of DNA can provide a mechanistic link through every aspect of DNA biology from replication to transcription to translation.
Studying ancient DNA allows us to retrace the evolutionary history of human pathogens, such as Mycobacterium leprae, the main causative agent of leprosy. Leprosy is one of the oldest recorded and most stigmatizing diseases in human history. The disease was prevalent in Europe until the 16th century and is still endemic in many countries with over 200,000 new cases reported annually. Previous worldwide studies on modern and European medieval M. leprae genomes revealed that they cluster into several distinct branches of which two were present in medieval Northwestern Europe. In this study, we analyzed 10 new medieval M. leprae genomes including the so far oldest M. leprae genome from one of the earliest known cases of leprosy in the United KingdomÐa skeleton from the Great Chesterford cemetery with a calibrated age of 415±545 C.E. This dataset provides a genetic time transect of M. leprae diversity in Europe over the past 1500 years. We find M. leprae strains from four distinct branches to be present in the Early Medieval Period, and strains from three different branches were detected within a single cemetery from the High Medieval Period. Altogether these findings suggest a higher genetic diversity of M. leprae strains in medieval Europe at various time points than previously assumed. The resulting more complex picture of the past phylogeography of leprosy in Europe impacts current phylogeographical models of M. leprae dissemination. It suggests alternative models for the past spread of leprosy such as a wide spread prevalence of strains from different branches in Eurasia already in Antiquity or maybe even an origin in Western Eurasia. Furthermore, these results highlight how studying ancient M. leprae strains improves understanding the history of leprosy worldwide.
Leprosy was endemic in Europe until the Middle Ages. Using DNA array capture, we have obtained genome sequences of Mycobacterium leprae from skeletons of five medieval leprosy cases from the United Kingdom, Sweden, and Denmark. In one case, the DNA was so well preserved that full de novo assembly of the ancient bacterial genome could be achieved through shotgun sequencing alone. The ancient M. leprae sequences were compared with those of 11 modern strains, representing diverse genotypes and geographic origins. The comparisons revealed remarkable genomic conservation during the past 1000 years, a European origin for leprosy in the Americas, and the presence of an M. leprae genotype in medieval Europe now commonly associated with the Middle East. The exceptional preservation of M. leprae biomarkers, both DNA and mycolic acids, in ancient skeletons has major implications for palaeomicrobiology and human pathogen evolution.
We have examined a 5th to 6th century inhumation from Great Chesterford, Essex, UK. The incomplete remains are those of a young male, aged around 21-35 years at death. The remains show osteological evidence of lepromatous leprosy (LL) and this was confirmed by lipid biomarker analysis and ancient DNA (aDNA) analysis, which provided evidence for both multi-copy and single copy loci from the Mycobacterium leprae genome. Genotyping showed the strain belonged to the 3I lineage, but the Great Chesterford isolate appeared to be ancestral to 3I strains found in later medieval cases in southern Britain and also continental Europe. While a number of contemporaneous cases exist, at present, this case of leprosy is the earliest radiocarbon dated case in Britain confirmed by both aDNA and lipid biomarkers. Importantly, Strontium and Oxygen isotope analysis suggest that the individual is likely to have originated from outside Britain. This potentially sheds light on the origins of the strain in Britain and its subsequent spread to other parts of the world, including the Americas where the 3I lineage of M. leprae is still found in some southern states of America.
Human leprosy is primarily caused by Mycobacterium leprae, but also by the related‘M. lepromatosis’. Ancient leprosy can be recognised in archaeological materials by thepaleopathology associated with multi-bacillary or lepromatous forms of the disease. WholeM. leprae genomes have been obtained from human skeletons, and diagnostic aDNA frag-ments have been recovered. The derived M. leprae phylogenies, based on single nucleotidepolymorphisms, mirror past human migrations, as M. leprae is usually an obligate pathogen.The detection of M. leprae in historical leprosy cases is assisted by the hydrophobic M. lepraecell envelope, which is composed of unusual lipids that can be used as specific biomarkers.Lipid biomarkers are more stable than aDNA and can be detected directly without amplifi-cation. Indigenous human leprosy is extinct in Western Europe, but recently, both M. lepraeand ‘M. lepromatosis’ were found in British red squirrels. Leprosy may also be found in nine-banded armadillos (Dasypus novemcinctus) where it can cause a zoonotic human infection.Certain leprosy-like diseases, caused by uncultivable species in cats, for example, may berelated to M. leprae. The closest extant relatives of leprosy bacilli are probably members of theM. haemophilum taxon, emerging pathogens with genomic and lipid biomarker similarities.
Purpose. A woman's skull, exhibiting features of lepromatous leprosy (LL), was recovered from a garden in Hoxne, Suffolk. The absence of post crania and lack of formal excavation meant that diagnosis and dating was uncertain. The aim of this research was to confirm the diagnosis using biomolecular means and second, to place it in context with other British leprosy cases using SNP genotyping and radiocarbon dating. Methodology. Bone from the skull was analysed by ancient DNA (aDNA) methods and subjected to radiocarbon dating. As a result, stable carbon and nitrogen isotope values were produced, both useful for assessing aspects of the woman's diet. Results/Key findings. aDNA confirmed the presence of mycobacterium leprae and genotyping demonstrated an ancestral variant of subtype 3I, the same lineage recently identified in living squirrels in the south of England. Radiocarbon dating revealed the woman lived approximately between 885-1015 AD, providing evidence for endurance of this subtype in East Anglia, having been previously identified as early as the fifth-sixth century (Great Chesterford) and as late as the thirteenth century (Ipswich). Conclusions. The confirmation of a new pre-Norman leprosy case in East Anglia is of interest as this is where a high proportion of cases are located. Possible factors for this may include preservation and excavation biases, population density, but also connection and trade, possibly of fur, with the continent. Future research on other British LL cases should focus on exploring these aspects to advance understanding of the disease's history, here and on the continent.
Background Leprosy has afflicted humankind throughout history leaving evidence in both early texts and the archaeological record. In Britain, leprosy was widespread throughout the Middle Ages until its gradual and unexplained decline between the 14th and 16th centuries. The nature of this ancient endemic leprosy and its relationship to modern strains is only partly understood. Modern leprosy strains are currently divided into 5 phylogenetic groups, types 0 to 4, each with strong geographical links. Until recently, European strains, both ancient and modern, were thought to be exclusively type 3 strains. However, evidence for type 2 strains, a group normally associated with Central Asia and the Middle East, has recently been found in archaeological samples in Scandinavia and from two skeletons from the medieval leprosy hospital (or leprosarium) of St Mary Magdalen, near Winchester, England. Results Here we report the genotypic analysis and whole genome sequencing of two further ancient M. leprae genomes extracted from the remains of two individuals, Sk14 and Sk27, that were excavated from 10th-12th century burials at the leprosarium of St Mary Magdalen. DNA was extracted from the surfaces of bones showing osteological signs of leprosy. Known M. leprae polymorphisms were PCR amplified and Sanger sequenced, while draft genomes were generated by enriching for M. leprae DNA, and Illumina sequencing. SNP-typing and phylogenetic analysis of the draft genomes placed both of these ancient strains in the conserved type 2 group, with very few novel SNPs compared to other ancient or modern strains. Conclusions The genomes of the two newly sequenced M. leprae strains group firmly with other type 2F strains. Moreover, the M. leprae strain most closely related to one of the strains, Sk14, in the worldwide phylogeny is a contemporaneous ancient St Magdalen skeleton, vividly illustrating the epidemic and clonal nature of leprosy at this site. The prevalence of these type 2 strains indicates that type 2F strains, in contrast to later European and associated North American type 3 isolates, may have been the co-dominant or even the predominant genotype at this location during the 11th century.
Nine burials excavated from the Magdalen Hill Archaeological Research Project (MHARP) in Winchester, UK, showing skeletal signs of lepromatous leprosy (LL) have been studied using a multidisciplinary approach including osteological, geochemical and biomolecular techniques. DNA from Mycobacterium leprae was amplified from all nine skeletons but not from control skeletons devoid of indicative pathology. In several specimens we corroborated the identification of M. leprae with detection of mycolic acids specific to the cell wall of M. leprae and persistent in the skeletal samples. In five cases, the preservation of the material allowed detailed genotyping using single-nucleotide polymorphism (SNP) and multiple locus variable number tandem repeat analysis (MLVA). Three of the five cases proved to be infected with SNP type 3I-1, ancestral to contemporary M. leprae isolates found in southern states of America and likely carried by European migrants. From the remaining two burials we identified, for the first time in the British Isles, the occurrence of SNP type 2F. Stable isotope analysis conducted on tooth enamel taken from two of the type 3I-1 and one of the type 2F remains revealed that all three individuals had probably spent their formative years in the Winchester area. Previously, type 2F has been implicated as the precursor strain that migrated from the Middle East to India and South-East Asia, subsequently evolving to type 1 strains. Thus we show that type 2F had also spread westwards to Britain by the early medieval period.
The remains of a 3-5 year-old child from the late mediaeval cemetery serving the Priory of St. Peter and St. Paul, Taunton, Somerset, UK was the subject of an aDNA study. The aim was to distinguish between two differential diagnoses suggested by earlier osteological examination of the remains; either tuberculosis or Langerhans cell histiocytosis. The remains tested positive for MTB complex markers, corroborating this diagnosis reached on osteological grounds. Based on positivity for the mtp40 element and a deletion in the pks15/1 locus, we conclude that infection was due to a strain of the human pathogen M.tuberculosis belonging to lineage 4. Although DNA recovered from the case was heavily fragmented, sex determination by amelogenin PCR suggested these are the remains of a young male child. The findings are discussed considering additions to the literature since the original report. Descriptions of tuberculosis in children from this period are rare and burial Sk2077 represents the first UK example of a pre-adolescent individual to have a molecular diagnosis combined with osteological pathology. This provides an important reference of childhood tuberculosis and insight into the likely presence of tuberculosis in the mediaeval adult population served by this cemetery.
Elevated expression of heat-shock proteins (HSPs) can benefit a microbial pathogen struggling to penetrate host defenses during infection, but at the same time might provide a crucial signal alerting the host immune system to its presence. To determine which of these effects predominate, we constructed a mutant strain of Mycobacterium tuberculosis that constitutively overexpresses Hsp70 proteins. Although the mutant was fully virulent in the initial stage of infection, it was significantly impaired in its ability to persist during the subsequent chronic phase. Induction of microbial genes encoding HSPs might provide a novel strategy to boost the immune response of individuals with latent tuberculosis infection.
Tuberculosis remains the most pervasive infectious disease and the recent emergence of drug-resistant strains emphasizes the need for more efficient drug treatments. A key feature of pathogenesis, conserved between the human pathogen Mycobacterium tuberculosis and the model pathogen Mycobacterium marinum, is the metabolic switch to lipid catabolism and altered expression of virulence genes at different stages of infection. This study aims to identify genes involved in sustaining viable intracellular infection. We applied transposon sequencing (Tn-Seq) to M. marinum, an unbiased genome-wide strategy combining saturation insertional mutagenesis and high-throughput sequencing. This approach allowed us to identify the localization and relative abundance of insertions in pools of transposon mutants. Gene essentiality and fitness cost of mutations were quantitatively compared between in vitro growth and different stages of infection in two evolutionary distinct phagocytes, the amoeba Dictyostelium discoideum and the murine BV2 microglial cells. In the M. marinum genome, 57% of TA sites were disrupted and 568 genes (10.2%) were essential, which is comparable to previous Tn-Seq studies on M. tuberculosis and M. bovis. Major pathways involved in the survival of M. marinum during infection of D. discoideum are related to DNA damage repair, lipid and vitamin metabolism, the type VII secretion system (T7SS) ESX-1, and the Mce1 lipid transport system. These pathways, except Mce1 and some glycolytic enzymes, were similarly affected in BV2 cells. These differences suggest subtly distinct nutrient availability or requirement in different host cells despite the known predominant use of lipids in both amoeba and microglial cells.IMPORTANCEThe emergence of biochemically and genetically tractable host model organisms for infection studies holds the promise to accelerate the pace of discoveries related to the evolution of innate immunity and the dissection of conserved mechanisms of cell-autonomous defenses. Here, we have used the genetically and biochemically tractable infection model system Dictyostelium discoideum/Mycobacterium marinum to apply a genome-wide transposon-sequencing experimental strategy to reveal comprehensively which mutations confer a fitness advantage or disadvantage during infection and compare these to a similar experiment performed using the murine microglial BV2 cells as host for M. marinum to identify conservation of virulence pathways between hosts.
Stress-induced adaptations requiremultiple levels of regulation in all organisms to repair cellular damage. In the present study we evaluated the genome-wide transcriptional and translational changes following heat stress exposure in the soil-dwelling model actinomycete bacterium, Streptomyces coelicolor. The combined analysis revealed an unprecedented level of translational control of gene expression, deduced through polysome profiling, in addition to transcriptional changes. Our data show little correlation between the transcriptome and ‘translatome’; while an obvious downward trend in genome wide transcription was observed, polysome associated transcripts following heat-shock showed an opposite upward trend. A handful of key protein players, including the major molecular chaperones and proteases were highly induced at both the transcriptional and translational level following heat-shock, a phenomenon known as ‘potentiation’. Many other transcripts encoding cold-shock proteins, ABC-transporter systems, multiple transcription factors weremore highly polysome-associated following heat stress; interestingly, these protein families were not induced at the transcriptional level and therefore were not previously identified as part of the stress response. Thus, stress coping mechanisms at the level of gene expression in this bacterium go well beyond the induction of a relatively small number of molecular chaperones and proteases in order to ensure cellular survival at non-physiological temperatures.
Mycobacterium tuberculosis infects a third of the world's population. Primary tuberculosis involving active fast bacterial replication is often followed by asymptomatic latent tuberculosis, which is characterised by slow or non-replicating bacteria. Reactivation of the latent infection involving a switch back to active bacterial replication can lead to post-primary transmissible tuberculosis. Mycobacterial mechanisms involved in slow growth or switching growth rate provide rational targets for the development of new drugs against persistent mycobacterial infection. Using chemostat culture to control growth rate, we screened a transposon mutant library by Transposon site hybridization (TraSH) selection to define the genetic requirements for slow and fast growth of Mycobacterium bovis (BCG) and for the requirements of switching growth rate. We identified 84 genes that are exclusively required for slow growth (69 hours doubling time) and 256 genes required for switching from slow to fast growth. To validate these findings we performed experiments using individual M. tuberculosis and M. bovis BCG knock out mutants. We have demonstrated that growth rate control is a carefully orchestrated process which requires a distinct set of genes encoding several virulence determinants, gene regulators, and metabolic enzymes. The mce1 locus appears to be a component of the switch to slow growth rate, which is consistent with the proposed role in virulence of M. tuberculosis. These results suggest novel perspectives for unravelling the mechanisms involved in the switch between acute and persistent TB infections and provide a means to study aspects of this important phenomenon in vitro.
In low-resource settings with high tuberculosis (TB) burdens, lack of rapid diagnostic methods for detection and differentiation of complex (MTBC) is a major challenge affecting TB management. This study utilized comparative genomic analyses of MTBC lineages; , Lineages 5/6 and to identify lineage-specific genes. Primers were designed for the development of a Multiplex PCR assay which was successful in differentiating the MTBC lineages. There was no cross-reaction with other respiratory pathogens tested. Validation of the assay using clinical samples was performed with sputum DNA extracts from 341 clinically confirmed active TB patients. It was observed that 24.9% of cases were caused by , while L5 & L6 reported 9.0% and 14.4%, respectively. infection was the least frequently detected lineage with 1.8%. Also, 27.0% and 17.0% of the cases were PCR negative and unspeciated, respectively. However, mixed-lineage TB infections were recorded at a surprising 5.9%. This multiplex PCR assay will allow speciation of MTBC lineages in low-resource regions, providing rapid differentiation of TB infections to select appropriate medication at the earliest possible time point. It will also be useful in epidemiological surveillance studies providing reliable information on the prevalence of TB lineages as well as identifying difficult to treat cases of mixed-lineage tuberculosis infections.
BACKGROUND: Mycobacterium tuberculosis continues to kill more people than any other bacterium. Although its archetypal host cell is the macrophage, it also enters, and survives within, dendritic cells (DCs). By modulating the behaviour of the DC, M. tuberculosis is able to manipulate the host's immune response and establish an infection. To identify the M. tuberculosis genes required for survival within DCs we infected primary human DCs with an M. tuberculosis transposon library and identified mutations with a reduced ability to survive. RESULTS: Parallel sequencing of the transposon inserts of the surviving mutants identified a large number of genes as being required for optimal intracellular fitness in DCs. Loci whose mutation attenuated intracellular survival included those involved in synthesising cell wall lipids, not only the well-established virulence factors, pDIM and cord factor, but also sulfolipids and PGL, which have not previously been identified as having a direct virulence role in cells. Other attenuated loci included the secretion systems ESX-1, ESX-2 and ESX-4, alongside many PPE genes, implicating a role for ESX-5. In contrast the canonical ESAT-6 family of ESX substrates did not have intra-DC fitness costs suggesting an alternative ESX-1 associated virulence mechanism. With the aid of a gene-nutrient interaction model, metabolic processes such as cholesterol side chain catabolism, nitrate reductase and cysteine-methionine metabolism were also identified as important for survival in DCs. CONCLUSION: We conclude that many of the virulence factors required for survival in DC are shared with macrophages, but that survival in DCs also requires several additional functions, such as cysteine-methionine metabolism, PGLs, sulfolipids, ESX systems and PPE genes.
Tn 4560 (8.6 kb) was derived from Tn 4556, a Tn 3-like element from Streptomyces fradiae. It contains a viomycin resistance gene that has not been used previously for selection in mycobacteria. Tn 4560, cloned in a Streptomyces plasmid, was introduced by electroporation into Mycobacterium smegmatis mc 2155. Tn 4560 transposed into the host genome: there was no obvious target sequence preference, and insertions were in or near several conserved open reading frames. The insertions were located far apart on different AseI macrorestriction fragments. Unexpectedly, the transposon delivery plasmid, pUC1169, derived from the Streptomyces multicopy plasmid pIJ101, replicated partially in M. smegmatis, but was lost spontaneously during subculture. Replication of pUC1169 probably contributed to the relatively high efficiency of Tn 4560 delivery: up to 28% of the potential M. smegmatis transformants acquired a stable transposon insertion. The data indicated that Tn 4560 may be useful for random mutagenesis of M. smegmatis.
Background BCG is the most widely used vaccine of all time and remains the only licensed vaccine for use against tuberculosis in humans. BCG also protects other species such as cattle against tuberculosis, but due to its incompatibility with current tuberculin testing regimens remains unlicensed. BCG’s efficacy relates to its ability to persist in the host for weeks, months or even years after vaccination. It is unclear to what degree this ability to resist the host’s immune system is maintained by a dynamic interaction between the vaccine strain and its host as is the case for pathogenic mycobacteria. Results To investigate this question, we constructed transposon mutant libraries in both BCG Pasteur and BCG Danish strains and inoculated them into bovine lymph nodes. Cattle are well suited to such an assay, as they are naturally susceptible to tuberculosis and are one of the few animal species for which a BCG vaccination program has been proposed. After three weeks, the BCG were recovered and the input and output libraries compared to identify mutants with in vivo fitness defects. Less than 10% of the mutated genes were identified as affecting in vivo fitness, they included genes encoding known mycobacterial virulence functions such as mycobactin synthesis, sugar transport, reductive sulphate assimilation, PDIM synthesis and cholesterol metabolism. Many other attenuating genes had not previously been recognised as having a virulence phenotype. To test these genes, we generated and characterised three knockout mutants that were predicted by transposon mutagenesis to be attenuating in vivo: pyruvate carboxylase, a hypothetical protein (BCG_1063), and a putative cyclopropane-fatty-acyl-phospholipid synthase. The knockout strains survived as well as wild type during in vitro culture and in bovine macrophages, yet demonstrated marked attenuation during passage in bovine lymph nodes confirming that they were indeed involved in persistence of BCG in the host. Conclusion These data show that BCG is far from passive during its interaction with the host, rather it continues to employ its remaining virulence factors, to interact with the host’s innate immune system to allow it to persist, a property that is important for its protective efficacy.
Relatively little is known of leprosy in Medieval Ireland; as an island located at the far west of Europe it has the potential to provide interesting insights in relation to the historical epidemiology of the disease. To this end the study focuses on five cases of probable leprosy identified in human skeletal remains excavated from inhumation burials. Three of the individuals derived from the cemetery of St Michael Le Pole, Golden Lane, Dublin, while single examples were also identified from Ardreigh, Co. Kildare, and St Patrick's Church, Armoy, Co. Antrim. The individuals were radiocarbon dated and examined biomolecularly for evidence of either of the causative pathogens, M. leprae or M. lepromatosis. Oxygen and strontium isotopes were measured in tooth enamel and rib samples to determine where the individuals had spent their formative years and to ascertain if they had undertaken any recent migrations. We detected M. leprae DNA in the three Golden Lane cases but not in the probable cases from either Ardreigh Co. Kildare or Armoy, Co. Antrim. M. lepromatosis was not detected in any of the burals. DNA preservation was sufficiently robust to allow genotyping of M. leprae strains in two of the Golden Lane burials, SkCXCV (12-13th century) and SkCCXXX (11-13th century). These strains were found to belong on different lineages of the M. leprae phylogenetic tree, namely branches 3 and 2 respectively. Whole genome sequencing was also attempted on these two isolates with a view to gaining further information but poor genome coverage precluded phylogenetic analysis. Data from the biomolecular study was combined with osteological, isotopic and radiocarbon dating to provide a comprehensive and multidisciplinary study of the Irish cases. Strontium and oxygen isotopic analysis indicate that two of the individuals from Golden Lane (SkCXLVIII (10-11th century) and SkCXCV) were of Scandinavian origin, while SkCCXXX may have spent his childhood in the north of Ireland or central Britain. We propose that the Vikings were responsible for introducing leprosy to Ireland. This work adds to our knowledge of the likely origins of leprosy in Medieval Ireland and will hopefully stimulate further research into the history and spread of this ancient disease across the world.
We present here the use of targeted, long-read sequencing of the myostatin (MSTN) gene as a model to detect potential gene editing events in Thoroughbred horses. MSTN is a negative regulator of muscle development, making the gene a prime candidate target for gene doping. By sequencing the complete gene in one PCR product, we can catalogue all mutations without the need to produce short-fragment libraries. A panel of reference material fragments with defined mutations was constructed and successfully sequenced by both Oxford Nanopore and Illumina-based methods, showing that gene doping editing events can be detected using this technology. To ascertain the normal variation within the population, we sequenced the MSTN gene in 119 UK Thoroughbred horses. Variants from the reference genome were assigned to haplotypes and eight distinct patterns, designated Hap1 (reference genome) to Hap8, were determined with haplotypes Hap2 and Hap3 (which includes the 'speed gene' variant) being far the most prevalent. Hap3 was most abundant in flat-racing horses, whereas Hap2 was most abundant in jump-racing. Within this data set, results for 105 racehorses from out-of-competition sampling were compared between matrices of extracted DNA and direct PCR of whole blood from lithium heparin gel tubes, and strong agreement was found between the two methods. The direct-blood PCR was achieved without compromising the sample prior to plasma separation for analytical chemistry, and could thus be used as part of a routine screening workflow for gene editing detection.
Background Severe acute respiratory syndrome coronavirus 2 (SARS-CoV-2) RNA quantities, measured by reverse transcription quantitative PCR (RT-qPCR), have been proposed to stratify clinical risk or determine analytical performance targets. We investigated reproducibility and how setting diagnostic cutoffs altered the clinical sensitivity of coronavirus disease 2019 (COVID-19) testing. Methods Quantitative SARS-CoV-2 RNA distributions [quantification cycle (Cq) and copies/mL] from more than 6000 patients from 3 clinical laboratories in United Kingdom, Belgium, and the Republic of Korea were analyzed. Impact of Cq cutoffs on clinical sensitivity was assessed. The June/July 2020 INSTAND external quality assessment scheme SARS-CoV-2 materials were used to estimate laboratory reported copies/mL and to estimate the variation in copies/mL for a given Cq. Results When the WHO-suggested Cq cutoff of 25 was applied, the clinical sensitivity dropped to about 16%. Clinical sensitivity also dropped to about 27% when a simulated limit of detection of 10(6) copies/mL was applied. The interlaboratory variation for a given Cq value was >1000 fold in copies/mL (99% CI). Conclusion While RT-qPCR has been instrumental in the response to COVID-19, we recommend Cq (cycle threshold or crossing point) values not be used to set clinical cutoffs or diagnostic performance targets due to poor interlaboratory reproducibility; calibrated copy-based units (used elsewhere in virology) offer more reproducible alternatives. We also report a phenomenon where diagnostic performance may change relative to the effective reproduction number. Our findings indicate that the disparities between patient populations across time are an important consideration when evaluating or deploying diagnostic tests. This is especially relevant to the emergency situation of an evolving pandemic.
Due to the ease of collection, transport and storage, the use of dried blood spots (DBS) offers an attractive alternative matrix for detection of the abuse of gene therapy, otherwise known as gene doping. This study evaluated the recovery, extraction efficiency and resulting detection capability of DNA from DBS by evaluating different target types, DNA extraction kits, the number of punches and blood tube preservatives. The long-term storage stability of low-copy-number transgene targets in DBS was not assessed in this study but would be noteworthy to investigate further. DNA was quantified using two detection methods: qPCR and digital PCR (dPCR). Using six punches with the Qiagen Investigator kit gave the best overall DNA yield compared with other extraction methods. Including three punches, however, gave better DNA extraction efficiency. Reference material could be detected using qPCR and dPCR in DBS spiked with 5000 copies/mL of blood (approximately 15 copies per 3 mm of punch). The optimal DNA extraction protocol was used on DBS samples from a custom recombinant adeno-associated virus administration study and showed successful detection of vector targets in DBS samples. DNA extraction methods for dried blood spots (DBS) were evaluated to determine the suitability of the use of DBS as an alternative matrix for transgene detection towards gene doping screening. DNA was quantified using two detection methods: qPCR and dPCR. Using the Qiagen Investigator kit for DNA extraction with six DBS punches gave a better recovery of targets than three. However, three punches gave better extraction efficiency. DNA can be detected down to 5000 copies/mL of blood using qPCR and dPCR. image
M.leprae is one of the two causative agents of human leprosy; the other being M.lepromatosis. Like M.tuberculosis complex species and other pathogens, M.leprae exhibits phylogeography, meaning that strain variation is associated with geographical regions. Strain genotyping, usually achieved by studying single nucleotide polymorphisms (SNPs), can provide information on likely origins of the disease and human migration routes in antiquity. We have previously confirmed the presence of an M.leprae SNP-type 3 strain in G708, the skeleton of a 10th-11th century individual excavated from the deserted medieval village (DMV) site of Wharram Percy, Yorkshire, UK. The present study has applied additional SNP typing methods to this case to determine the leprosy subtype. This work shows the isolate responsible for leprosy in individual G708 was of the 3I-1 subtype but with some polymorphic loci indicative of other SNP types, which could be considered as ancestral to modern exemplars of this genotype.
An important feature of Mycobacterium tuberculosis pathogenesis is the ability to control cell death in infected host cells, including inhibition of apoptosis and stimulation of necrosis. Recently an alternative form of programmed cell death, necroptosis, has been described where necrotic cell death is induced by apoptotic stimuli under conditions where apoptotic execution is inhibited. We show for the first time that M. tuberculosis and TNFα synergise to induce necroptosis in murine fibroblasts via RIPK1-dependent mechanisms and characterized by phosphorylation of Ser345 of the MLKL necroptosis death effector. However, in murine macrophages M. tuberculosis and TNFα induce non-necroptotic cell death that is RIPK1-dependent but independent of MLKL phosphorylation. Instead, M. tuberculosis-infected macrophages undergo RIPK3-dependent cell death which occurs both in the presence and absence of TNFα and involves the production of mitochondrial ROS. Immunocytochemical staining for MLKL phosphorylation further demonstrated the occurrence of necroptosis in vivo in murine M. tuberculosis granulomas. Phosphorylated- MLKL immunoreactivity was observed associated with the cytoplasm and nucleus of fusiform cells in M. tuberculosis lesions but not in proximal macrophages. Thus whereas pMLKL-driven necroptosis does not appear to be a feature of M. tuberculosis-infected macrophage cell death, it may contribute to TNFα-induced cytotoxicity of the lung stroma and therefore contribute to necrotic cavitation and bacterial dissemination.
Mycobacterium bovis is the causative agent of bovine tuberculosis and the predominant cause of zoonotic tuberculosis in people. Bovine tuberculosis occurs in farmed cattle but also in a variety of wild animals, which form a reservoir of infection. Although direct transmission of tuberculosis occurs between mammals, the low frequency of contact between different host species and abundant shedding of bacilli by infected animals suggests an infectious route via environmental contamination. Other intracellular pathogens that transmit via the environment deploy strategies to survive or exploit predation by environmental amoebae. To explore if M. bovis has this capability, we investigated its interactions with the soil and dung-dwelling amoeba, Dictyostelium discoideum. We demonstrated that M. bovis evades phagocytosis and destruction by D. discoideum and actively transits through the amoeba using the ESX-1 Type VII Secretion System as part of a programme of mechanisms, many of which have been co-opted as virulence factors in the mammalian host. This capacity of M. bovis to utilise an environmental stage between mammalian hosts may enhance its transmissibility. In addition, our data provide molecular evidence to support an evolutionary role for amoebae as training grounds for the pathogenic M. tuberculosis complex.
Diagnosis of leprosy and tuberculosis in archaeological material is most informative when based upon entire genomes. Ancient DNA (aDNA) is often degraded but amplification of specific fragments also provides reliable diagnoses. Cell wall lipid biomarkers can distinguish ancient leprosy from tuberculosis and DNA extraction residues can be utilized. The diagnostic power of combined aDNA and lipid biomarkers is illustrated by key cases of ancient leprosy and/or tuberculosis. Human tuberculosis was demonstrated in a woman and child from Atlit-Yam (~9 ka) in the Eastern Mediterranean and in the 600 BCE Egyptian “Granville” mummy. Both aDNA and lipids confirmed Pleistocene tuberculosis in a ~17 ka bison from Natural Trap Cave, Wyoming. Leprosy is exemplified by cases from Winchester (10th–12th centuries CE) and Great Chesterford (5th–6th centuries CE). A mixed infection from Kiskundorozsma, Hungary (7th century CE) allowed lipid biomarkers to assess the relative load of leprosy and tuberculosis. Essential protocols for aDNA amplification and analysis of mycolic, mycolipenic, mycocerosic acid, and phthiocerol lipid biomarkers are summarized. Diagnoses of ancient mycobacterial disease can be extended beyond the reach of whole genomics by combinations of aDNA amplification and lipid biomarkers, with sole use of the latter having the potential to recognize even older cases.
To establish a biological profile and disease aetiologies for one of four burials recovered during a Time Team dig at the St. Mary Magdalen leprosarium , Winchester, UK in AD 2000. Osteological techniques were applied to estimate age at death, biological sex, stature and pathology. Visual assessment of the material was supplemented by radiographic examination. Evidence for leprosy DNA was sought using ancient DNA (aDNA) analysis. The remains are those of a male individual excavated from a west–east aligned grave. The skeleton shows signs of two pathologies. Remodelling of the rhino-maxillary area and degenerative changes to small bones of the feet and reactive bone on the distal lower limbs suggest a multibacillary form of leprosy, whereas the right tibia and fibula show the presence of a primary neoplasm identified as an osteosarcoma. The aDNA study confirmed presence of Mycobacterium leprae in several skeletal elements, and the strain was genotyped to the 3I lineage, one of two main SNP types present in mediaeval Britain and ancestral to extant strains in America. This is a rare documentation of leprosy in association with a primary neoplasm.
Chaperone and protease systems play essential roles in cellular homeostasis and have vital functions in controlling the abundance of specific cellular proteins involved in processes such as transcription, replication, metabolism and virulence. Bacteria have evolved accurate regulatory systems to control the expression and function of chaperones and potentially destructive proteases. Here, we have used a combination of transcriptomics, proteomics and targeted mutagenesis to reveal that the clp gene regulator (ClgR) of Mycobacterium tuberculosis activates the transcription of at least ten genes, including four that encode protease systems (ClpP1/C, ClpP2/C, PtrB and HtrA-like protease Rv1043c) and three that encode chaperones (Acr2, ClpB and the chaperonin Rv3269). Thus, M. tuberculosis ClgR controls a larger network of protein homeostatic and regulatory systems than ClgR in any other bacterium studied to date. We demonstrate that ClgR-regulated transcriptional activation of these systems is essential for M. tuberculosis to replicate in macrophages. Furthermore, we observe that this defect is manifest early in infection, as M. tuberculosis lacking ClgR is deficient in the ability to control phagosome pH 1 h post-phagocytosis.
Non-human primate models of Tuberculosis (TB) are one of the most commonly used within the experimental TB field because they closely mimic the whole spectrum of disease progression of human TB. However, the early cellular interactions of the pulmonary granuloma are still not well understood. The use of this model allows investigation into the early interactions of cells within pulmonary granulomas which cannot be undertaken in human samples. Pulmonary granulomas from rhesus and cynomolgus macaques from two timepoints post infection were categorised into categories 1 - 6 (early to late stage granulomas) and immunohistochemistry was used to identify CD68+ macrophages, CD3+ T cells and CD20+ B cells. Multinucleated giant cells and acid-fast bacilli were also quantified. At week four post infection, cynomolgus macaques were found to have more CD68+ cells than rhesus in all but category 1 granulomas. Cynomolgus also had a significantly higher percentage of CD20+ B cells in category 1 granulomas. At week twelve post infection, CD68+ cells were most abundant in category 4 and 5 granulomas in both species; however, there were no significant differences between them. CD3+ T cells and CD20+ B cells were significantly higher in the majority of granuloma categories in cynomolgus compared to rhesus. Multinucleated giant cells and acid-fast bacilli were most abundant in categories 5 and 6 at week 12 post challenge in both species. This study has identified the basic cellular composition and spatial distribution of immune cells within pulmonary granulomas in both rhesus and cynomolgus macaques over time. The data from this study will add to the knowledge already gained in this field and may inform future research on vaccines and therapeutics for TB.
Gene editing and subsequent cloning techniques offer great potential not only in genetic disease correction in domestic animals but also in livestock production by enhancement of desirable traits. The existence of the technology, however, leaves it open to potential misuse in performance-led sports such as horseracing and other equestrian events. Recent advances in equine gene editing, regarding the generation of gene-edited embryos using CRISPR/Cas9 technology and somatic cell nuclear transfer, have highlighted the need to develop tools to detect potential prohibited use of the technology. One possible method involves the characterisation of the mitochondrial genome (which is not routinely preserved during cloning) and comparing it with the sequence of the registered dam. We present here our approach to whole-mitochondrial sequencing using tiled long-range PCR and next-generation sequencing. To determine whether the background mutation rate in the mitochondrial genome could potentially confound results, we sequenced 10 sets of dam and foal duos. We found variation between duos but none within duos, indicating that this method is feasible for future screening systems. Analysis of WGS data from over 100 Thoroughbred horses revealed wide variation in the mitochondria sequence within the breed, further displaying the utility of this approach.
Tetrodotoxin (TTX), a potent neurotoxin mostly associated with pufferfish poisoning, is also found in bivalve shellfish. Recent studies into this emerging food safety threat reported TTX in a few, mainly estuarine, shellfish production areas in some European countries, including the United Kingdom. A pattern in occurrences has started to emerge, however the role of temperature on TTX has not been investigated in detail. Therefore, we conducted a large systematic TTX screening study, encompassing over 3500 bivalve samples collected throughout 2016 from 155 shellfish monitoring sites along the coast of Great Britain. Overall, we found that only 1.1 % of tested samples contained TTX above the reporting limit of 2 μg/kg whole shellfish flesh and these samples all originated from ten shellfish production sites in southern England. Subsequent continuous monitoring of selected areas over a five-year period showed a potential seasonal TTX accumulation in bivalves, starting in June when water temperatures reached around 15 °C. For the first time, satellite-derived data were also applied to investigate temperature differences between sites with and without confirmed presence of TTX in 2016. Although average annual temperatures were similar in both groups, daily mean values were higher in summer and lower in winter at sites where TTX was found. Here, temperature also increased significantly faster during late spring and early summer, the critical period for TTX. Our study supports the hypothesis that temperature is one of the key triggers of events leading to TTX accumulation in European bivalves. However, other factors are also likely to play an important role, including the presence or absence of a de novo biological source, which remains elusive.
Indirect immunofluorescent studies have been used to localize a glycoprotein (gp32) in the amphids of 2nd-stage juveniles (J2) of Meloidogyne incognita parasitic in the roots of tomato plants, male Meloidogyne javanica and some young adult female M. incognita. Immuno-electron microscopic studies showed an apparent absence of gp32 in the amphids of mature adult female M. incognita. Chemoattraction experiments demonstrated that the binding of gp32 antibodies to the amphidial secretions of infective J2 M. incognita partly impaired the ability of the nematodes to locate tomato roots.
ADP-ribosyltransferases use NAD+ to catalyse substrate ADP-ribosylation1, and thereby regulate cellular pathways or contribute to toxin-mediated pathogenicity of bacteria2-4. Reversible ADP-ribosylation has traditionally been considered a protein-specific modification5, but recent in vitro studies have suggested nucleic acids as targets6-9. Here we present evidence that specific, reversible ADP-ribosylation ofDNA on thymidine bases occurs in cellulo through the DarT-DarG toxin-antitoxin system, which is found in a variety of bacteria (including global pathogens such as Mycobacterium tuberculosis, enteropathogenic Escherichia coli and Pseudomonas aeruginosa)10. We report the structure ofDarT, which identifies this protein as a diverged member ofthe PARP family. We provide a set of high-resolution structures of this enzyme in ligand-free and pre- and post-reaction states, which reveals a specialized mechanism of catalysis that includes a key active-site arginine that extends the canonical ADP-ribosyltransferase toolkit. Comparison with PARP-HPF1, a well-established DNA repair protein ADP-ribosylation complex, offers insights into how the DarT class ofADP-ribosyltransferases evolved into specific DNA-modifying enzymes. Together, our structural and mechanistic data provide details ofthis PARP family member and contribute to a fundamental understanding of the ADP-ribosylation of nucleic acids. We also show that thymine-linked ADP-ribose DNA adducts reversed by DarG antitoxin (functioning as a noncanonical DNA repair factor) are used not only for targeted DNA damage to induce toxicity, but also as a signalling strategy for cellular processes. Using M. tuberculosis as an exemplar, we show that DarT-DarG regulates growth by ADP-ribosylation ofDNA at the origin of chromosome replication.
Indirect immunofluorescence studies using a rabbit polyclonal antiserum have been used to localize the presence of a 32 kDa glycoprotein in the region of the amphids of 2nd-stage juveniles of the root-knot nematode, Meloidogyne incognita. Similar immunoreactivity was also demonstrated in 5 other Meloidogyne species but was not found in representatives of 8 other nematode genera including the closely related cyst nematodes (Globodera and Heterodera). Immunoelectron microscopical studies have shown that the immunoreactivity in M. incognita is associated with the secretory material filling the amphidial channel and probably with the sheath cell.
PRRS control is hampered by the inadequacies of existing vaccines to combat the extreme diversity of circulating viruses. Since immune clearance of PRRSV infection may not be dependent on the development of neutralising antibodies and the identification of broadly- neutralising antibody epitopes have proven elusive we hypothesised that conserved T cell antigens represent potential candidates for development of a novel PRRS vaccine. Previously we had identified the M and NSP5 proteins as well-conserved targets of polyfunctional CD8 and CD4 T cells. To assess their vaccine potential, peptides representing M and NSP5 were encapsulated in hydrophobically-modified chitosan particles adjuvanted by incorporation of a synthetic multi-TLR2/TLR7 agonist and coated with a model B cell PRRSV antigen. For comparison, empty particles and adjuvanted particles encapsulating inactivated PRRSV-1
Introduction. We have examined four burials from the St Mary Magdalen mediaeval leprosarium cemetery in Winchester, Hampshire, UK. One (Sk.8) was a male child, two (Sk.45 and Sk.52) were adolescent females and the fourth (Sk.512) was an adult male. The cemetery was in use between the 10th and 12th centuries. All showed skeletal lesions of leprosy. Additionally, one of the two females (Sk.45) had lesions suggestive of multi-cystic tuberculosis and the second (Sk.52) of leprogenic odontodysplasia (LO), a rare malformation of the roots of the permanent maxillary incisors. Gap statement. Relatively little is known of the manifestations of lepromatous leprosy (LL) in younger individuals from the archaeological record. Aims and Methodology. To address this, we have used ancient DNA testing and osteological examination of the individuals, supplemented with X-ray and microcomputed tomography (micro-CT) scan as necessary to assess the disease status. Results and Conclusions. The presence of Mycobacterium leprae DNA was confirmed in both females, and genotyping showed SNP type 3I-1 strains but with a clear genotypic variation. We could not confirm Mycobacterium tuberculosis complex DNA in the female individual SK.45. High levels of M. leprae DNA were found within the pulp cavities of four maxillary teeth from the male child (Sk.8) with LO, consistent with the theory that the replication of M. leprae in alveolar bone may interfere with root formation at key stages of development. We report our biomolecular findings in these individuals and review the evidence this site has contributed to our knowledge of mediaeval leprosy.
Gene doping in horses is a threat to the fairness in sport and has serious implications for animal welfare. To investigate the effect of long-term storage on the detection of AAV in plasma and whole blood, samples from an administration study using an adeno-associated virus serotype 6 expressing green fluorescence protein (AAV6-GFP) were stored at -20 & DEG;C for 8 months before analysis. The AAV vector was detected in stored plasma samples, following the same detection profile as the fresh plasma samples. The stored blood showed lower overall DNA detection but followed the same detection profile as the plasma samples. This study provides confidence that re-analysing plasma samples and/or analysing a frozen 'B' sample with different matrix such as whole blood after prolonged storage will still result in the detection of gene doping material. Equine whole blood and plasma samples from an administration of AAV-GFP viral vector were stored at -20 & DEG;C for 8 months and analysed with qPCR and massively parallel sequencing. The vector detection in stored plasma samples followed the same detection profile as the fresh plasma samples with minimal degradation. Stored blood samples showed lower overall DNA detection but followed the same detection profile as the plasma samples. This study provides confidence in the detection of gene doping material when re-analysing samples and/or analysing 'B' samples for confirmatory analysis.image
The misuse of gene therapy by the introduction of transgenes via plasmid or viral vectors as a doping agent is an increasing concern in human and animal sports, not only in consideration to fair competition but also in potential detrimental effects to welfare. Doping events can be detected by polymerase chain reaction (PCR) amplification of a transgene-specific region of DNA. Quantitative real-time PCR (qPCR) is particularly suited to confirmatory investigations where precise limits of detection can be calculated. To fully validate a qPCR experiment, it is highly desirable to confirm the identity of the amplicon. Although post-PCR techniques such as melt curve and fragment size analysis can provide strong evidence that the amplicon is as expected, sequence identity confirmation may be beneficial as part of regulatory proceedings. We present here our investigation into two alternative processes for the direct assessment of qPCR products for five genes using next-generation sequencing: ligation of sequence-ready adapters to qPCR products and qPCR assays performed with primers tailed with Illumina flow cell binding sites. To fully test the robustness of the techniques at concentrations required for gene doping detection, we also calculated a putative limit of detection for the assays. Both ligated adapters and tailed primers were successful in producing sequence data for the qPCR products without further amplification. Ligated adapters are preferred, however, as they do not require re-optimisation of existing qPCR assays.
Bovine tuberculosis (bTB), a zoonosis mainly caused by Mycobacterium bovis has severe socio-economic consequences and impact on animal health. Host-pathogen interactions during M. bovis infection are poorly understood, especially early events which are difficult to follow in vivo. This study describes the utilisation of an in vitro co-culture model, comprising immortalised bovine alveolar type II (BATII) epithelial cells and bovine pulmonary arterial endothelial cells (BPAECs). When cultured at air-liquid interface, it was possible to follow the migration of live M. bovis Bacille Calmette-Guerin (BCG) and to observe interactions with each cell type, alongside cytokine release. Infection with BCG was shown to exert a detrimental effect primarily upon epithelial cells, with corresponding increases in IL8, TNF alpha, IL22 and IL17a cytokine release, quantified by ELISA. BCG infection increased expression of CD54, MHC Class I and II molecules in endothelial but not epithelial cells, which exhibited constitutive expression. The effect of peripheral blood mononuclear cell conditioned medium from vaccinated cattle upon apical-basolateral migration of BCG was examined by quantifying recovered BCG from the apical, membrane and basolateral fractions over time. The numbers of recovered BCG in each fraction were unaffected by the presence of PBMC conditioned medium, with no observable differences between vaccinated and naive animals.
We report on a Mycobacterium leprae genome isolated from the remains of an individual with lepromatous leprosy that were excavated from a 7th century Hungarian cemetery. We determined that the genome was from a SNP type 3K0 M. leprae strain, a lineage that diverged early from other M. leprae lineages. This is one of the earliest 3K0 M. leprae genomes to be sequenced to date. A number of novel SNPs as well as SNPs characteristic of the 3K0 lineage were confirmed by conventional PCR and Sanger sequencing. Recovery of accompanying human DNA from the burial was poor, particularly when compared to that of the pathogen. Modern 3K0 M. leprae strains have only been isolated from East Asia and the Pacific and so these findings require new scenarios to describe the origins and routes of dissemination of leprosy during antiquity that have resulted in the modern phylogeographical distribution of M. leprae.
An important mechanism of Mycobacterium tuberculosis pathogenesis is the ability to control cell death pathways in infected macrophages: apoptotic cell death is bactericidal, whereas necrotic cell death may facilitate bacterial dissemination and transmission.
Systems Biology has established numerous approaches for mechanistic modelling of molecular networks in the cell and a legacy of models. The current frontier is the integration of models expressed in different formalisms to address the multi-scale biological system organisation challenge. We present MUFINS software, implementing a unique set of approaches for multiformalism simulation of interaction networks. We extend the constraint-based modelling (CBM) framework by incorporation of linear inhibition constraints, enabling for the first time linear modelling of networks simultaneously describing gene regulation, signalling and whole-cell metabolism at steady state. We present a use case where a logical hypergraph model of a regulatory network is expressed by linear constraints and integrated with a Genome Scale Metabolic Network (GSMN) of mouse macrophage. We experimentally validate predictions, demonstrating application of our software in an iterative cycle of hypothesis generation, validation and model refinement. MUFINS incorporates an extended version of our Quasi Steady State Petri Net approach to integrate dynamic models with CBM, which we demonstrate through a dynamic model of cortisol signalling integrated with the human Recon2 GSMN and a model of nutrient dynamics in physiological compartments. Finally, we implement a number of methods for deriving metabolic states from ~omics data, including our new variant of the iMAT congruency approach. We compare our approach with iMAT through analysis of 262 individual tumour transcriptomes, recovering features of metabolic reprogramming in cancer. The software provides graphics user interface with network visualisation, which facilitates use by researchers who are not experienced in coding and mathematical modelling environments.
Tuberculosis (TB) caused by bacteria of the Mycobacterium tuberculosis complex remains one of the most important infectious diseases of mankind. Rifampicin is a first line drug used in multi- drug treatment of TB, however, the necessary duration of treatment with these drugs is long and development of resistance is an increasing impediment to treatment programmes. As a result, there is a requirement for research and development of new TB drugs, which can form the basis of new drug combinations, either due to their own anti- mycobacterial activity or by augmenting the activity of existing drugs such as rifampicin. This study describes a TnSeq analysis to identify mutants with enhanced sensitivity to sub- minimum inhibitory concentrations (MIC) of rifampicin. The rifampicin- sensitive mutants were disrupted in genes of a variety of functions and the majority fitted into three thematic groups: firstly, genes that were involved in DNA/RNA metabolism, secondly, genes involved in sensing and regulating mycobacterial cellular systems, and thirdly, genes involved in the synthesis and maintenance of the cell wall. Selection at two concentrations of rifampicin (1/250 and 1/62 MIC) demonstrated a dose response for mutants with statistically significant sensitivity to rifampicin. The dataset reveals mechanisms of how mycobacteria are innately tolerant to and initiate an adaptive response to rifampicin; providing putative targets for the development of adjunctive therapies that potentiate the action of rifampicin.
Bovine tuberculosis is an important animal health problem and the predominant cause of zoonotic tuberculosis worldwide. It results in serious economic burden due to losses in productivity and the cost of control programmes. Control could be greatly improved by the introduction of an efficacious cattle vaccine but the most likely candidate, BCG, has several limitations including variable efficacy. Augmentation of BCG with a subunit vaccine booster has been shown to increase protection but the selection of antigens has hitherto been left largely to serendipity. In the present study, we take a rational approach to identify the protective antigens of BCG, selecting a BCG transposon mutant library in naïve and BCG-vaccinated cattle. Ten mutants had increased relative survival in vaccinated compared to naïve cattle, consistent with loss of protective antigen targets making the mutants less visible to the BCG immune response. The immunogenicity of three putative protective antigens, BCG_0116, BCG_0205 (YrbE1B) and BCG_1448 (PPE20) was investigated using peptide pools and PBMCs from BCG vaccinated cattle. BCG vaccination induced PBMC to release elevated levels of IP10, IL-17a and IL-10 in response to all three antigens. Taken together, the data supports the further study of these antigens for use in subunit vaccines.